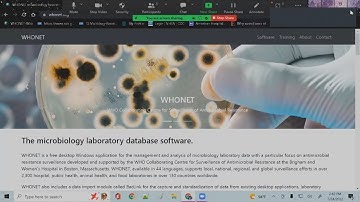
Introduction to WHONET

⬇ DOWNLOAD NOW
Kalau muncul iklan pop-up, tutup lalu klik tombol kembali
Download lagu WHONET Training Course - Module 1 - Introduction to WHONET secara gratis hanya untuk keperluan promosi. Dukung artis favorit kamu dengan membeli musik original di iTunes atau platform resmi lainnya.
 WHONET Module 1: Introduction to WHONET
WHONET Module 1: Introduction to WHONET
Introduction to WHONET
Introduction to WHONET
 WHONET Installation, Configuration, and Data Entry
WHONET Installation, Configuration, and Data Entry
 WHONET Training Course - Module 4 - Introduction to data analysis
WHONET Training Course - Module 4 - Introduction to data analysis
![Workshop On Installation & Analysis Of WHONET [Part - 1]](https://i.ytimg.com/vi/h_zWyWobtPw/hq720.jpg?sqp=-oaymwEjCOgCEMoBSFryq4qpAxUIARUAAAAAGAElAADIQj0AgKJDeAE=&rs=AOn4CLA8OcQVHORMohVGsOAhWZ3rSzzf5Q) Workshop On Installation & Analysis Of WHONET [Part - 1]
Workshop On Installation & Analysis Of WHONET [Part - 1]
 Using BacLink to import microbiology laboratory data into WHONET
Using BacLink to import microbiology laboratory data into WHONET
 WHONET Training Course - Module 2 - Laboratory Configuration
WHONET Training Course - Module 2 - Laboratory Configuration
 WHONET Training - 15Dec18
WHONET Training - 15Dec18